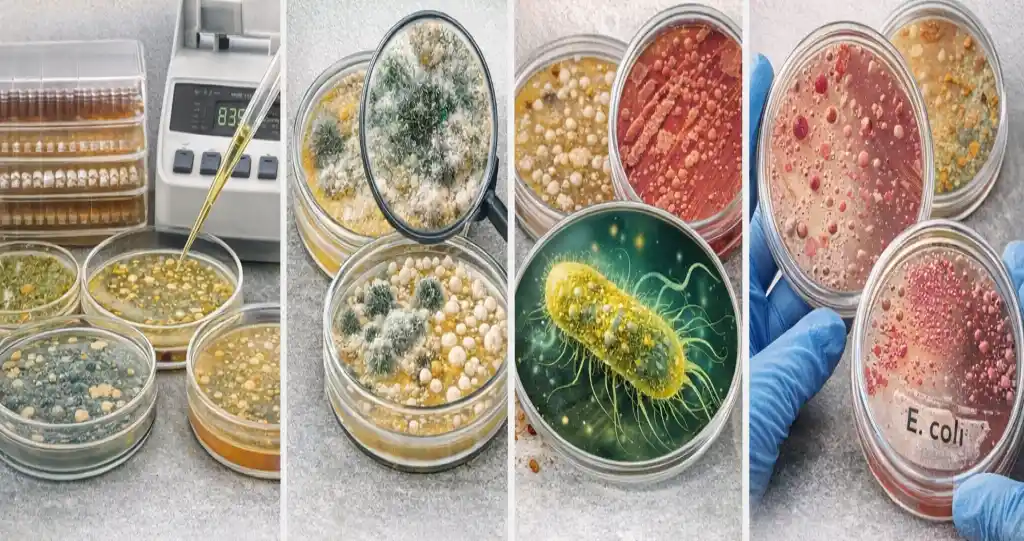
Types of food microbiology tests 1

آیا غذای شما واقعاً سالم است؟ | ۱۳ تست کلیدی میکروبیولوژی مواد غذایی

تا حالا فکر کردهاید غذایی که میخورید واقعاً سالم است؟ ممکن است بدون هیچ علامت ظاهری، میکروبهای خطرناک در آن پنهان باشند. تنها با تستهای میکروبیولوژی مواد غذایی که در آزمایشگاههای تخصصی انجام میشوند میتوان این خطرات را شناسایی و کنترل کرد.
میکروبیولوژی مواد غذایی علم بررسی میکروبها در غذاست؛ موجوداتی که میتوانند سلامت شما را تهدید کنند یا کیفیت محصول را کاهش دهند. انجام درست و منظم این تستها، بخشی از کنترل کیفی مواد غذایی است و نه تنها از بیماریهای منتقله از غذا جلوگیری میکند، بلکه کیفیت، ماندگاری و اعتماد مصرفکننده را تضمین میکند.
در این مسیر، ما قدم به قدم شما را با تستهای ضروری، روشهای کلاسیک و نوین و نکات عملی شناسایی پاتوژنها آشنا میکنیم. آمادهاید غذای خود را از دید علمی بررسی کنید؟
میکروبیولوژی مواد غذایی چیست؟
برای درک اهمیت تستهای میکروبی، ابتدا باید بدانیم میکروبیولوژی مواد غذایی دقیقاً چیست و چرا پایه تمام تصمیمهای علمی در صنایع غذایی محسوب میشود.
تعریف ساده و علمی میکروبیولوژی مواد غذایی
میکروبیولوژی مواد غذایی شاخهای از علوم غذایی است که به بررسی میکروارگانیسمها در غذا میپردازد؛ موجوداتی میکروسکوپی که میتوانند سلامت، کیفیت و ماندگاری مواد غذایی را تحت تأثیر قرار دهند.
این علم به بررسی موارد زیر میپردازد:
- مسیر ورود میکروبها به غذا
- شرایط رشد و تکثیر آنها
- روشهای شناسایی و کنترل حضورشان از طریق تستهای میکروبی
بدون دانش میکروبیولوژی، تصمیمگیری درباره سلامت غذا تنها بر اساس ظاهر، بو یا طعم انجام میشود؛ معیارهایی که قابل اعتماد نیستند.
تفاوت میکروارگانیسمهای مفید، فسادزا و بیماریزا
همه میکروبها در مواد غذایی یکسان نیستند و به سه گروه اصلی تقسیم میشوند:
- میکروارگانیسمهای مفید
این گروه به تولید غذاهای تخمیری کمک میکند، مانند باکتریهای اسیدلاکتیک در ماست و پنیر، که طعم، بافت و ارزش غذایی محصول را بهبود میبخشند. - میکروارگانیسمهای فسادزا
این باکتریها باعث تغییر بو، طعم، رنگ یا بافت غذا میشوند. اغلب بیماریزا نیستند، اما کیفیت و ماندگاری محصول را کاهش میدهند. - میکروارگانیسمهای بیماریزا (پاتوژنها)
خطرناکترین میکروبها هستند و ممکن است بدون هیچ علامت ظاهری در غذا حضور داشته باشند. نمونهها شامل سالمونلا، لیستریا و استافیلوکوکوس اورئوس هستند. تنها با تستهای میکروبی میتوان این پاتوژنها را شناسایی و کنترل کرد.

چرا صنایع غذایی بدون میکروبیولوژی فلج میشوند؟
بدون میکروبیولوژی، هیچ صنعتی نمیتواند محصولی ایمن و استاندارد تولید کند. این علم پایه ایمنی، کنترل کیفیت و رعایت استانداردهاست و نبود آن میتواند:
- منجر به خسارت مالی و آسیب به اعتبار برند شود
- سلامت مصرفکننده را به خطر بیندازد
کنترل میکروبی در خطوط تولید، تعیین حدود مجاز آلودگی، پیشگیری از فراخوان محصولات و رعایت قوانین، همه بر پایه دانش و تستهای میکروبی انجام میشوند.
به همین دلیل، میکروبیولوژی مواد غذایی گزینهای اختیاری نیست؛ بلکه زیرساخت حیاتی صنایع غذایی مدرن است.
چرا انجام تستهای میکروبیولوژی مواد غذایی ضروری است؟
ممکن است از خود بپرسید: «آیا واقعاً لازم است هر بار تست میکروبی انجام شود؟»
جواب کوتاه و علمی: کاملاً ضروری است.
چرا؟ بسیاری از آلودگیهای میکروبی نامرئی و بدون علامت هستند اما میتوانند سلامت مصرفکننده را بهشدت تهدید کنند. تنها راه اطمینان از ایمنی و کیفیت غذا، انجام منظم و اصولی تستهای میکروبیولوژی مواد غذایی است که پایه تصمیمگیری علمی در تولید محصول ایمن محسوب میشود.
پیشگیری از مسمومیتهای غذایی و حفاظت از سلامت
هدف اصلی تستهای میکروبی مواد غذایی، پیشگیری از مسمومیت و محافظت از سلامت مصرفکننده است. بسیاری از پاتوژنها، مانند سالمونلا و لیستریا، بدون تغییر در طعم یا ظاهر غذا وجود دارند اما میتوانند بیماریهای شدید ایجاد کنند.
با انجام این تستها، تولیدکنندگان قادر خواهند بود آلودگیهای پنهان را قبل از رسیدن محصول به دست شما شناسایی و از بحرانهای بهداشتی جلوگیری کنند.
انطباق با استانداردهای ملی و بینالمللی ایمنی غذا
تمام استانداردهای معتبر، مانند ISO و Codex Alimentarius، انجام تستهای میکروبیولوژی را الزامی میدانند. این تستها تنها راه ارزیابی حدود مجاز آلودگی میکروبی هستند و برای تولیدکنندگان داخلی و صادراتی، یک الزام قانونی و حرفهای محسوب میشوند، نه یک گزینه اختیاری.
افزایش ماندگاری و حفظ کیفیت محصول
تستهای میکروبی تنها برای شناسایی پاتوژنها نیستند؛ آنها میکروبهای فسادزا را نیز تشخیص میدهند که میتواند کیفیت و ماندگاری محصول را کاهش دهد.
با انجام منظم این تستها، تولیدکنندگان میتوانند:
- عوامل فساد را سریعتر شناسایی کنند
- شرایط نگهداری را بهینه کنند
- تاریخ مصرف دقیقتری تعیین کنند
نتیجه؟ ماندگاری بالاتر، کیفیت بهتر و کاهش ضایعات غذایی.
کاهش ریسک حقوقی و حفظ اعتبار برند
کنترل نکردن میکروبها میتواند پیامدهای حقوقی و مالی سنگینی داشته باشد. بسیاری از فراخوانهای محصولات غذایی ناشی از آلودگیهای میکروبی هستند و باعث آسیب به برند و اعتماد مصرفکننده میشوند.
انجام منظم تستهای میکروبی مواد غذایی نشان میدهد که تولیدکننده به ایمنی و استانداردها پایبند است و به کاهش ریسک حقوقی، جریمهها و از دست رفتن اعتبار کمک میکند.
دستهبندی تستهای میکروبیولوژی مواد غذایی
تستهای میکروبیولوژی را میتوان بر اساس هدف آزمایش به چند دسته اصلی تقسیم کرد. این دستهبندی به تولیدکنندگان و آزمایشگاهها کمک میکند تا بسته به نوع محصول، مرحله تولید و ریسکهای احتمالی، تست مناسب را انتخاب کنند.
تستهای شمارش میکروبی
تستهای شمارش میکروبی برای اندازهگیری تعداد میکروبها در غذا استفاده میشوند و پایهایترین بخش کنترل کیفیت مواد غذایی هستند. این تستها نشاندهنده سطح بهداشت، کیفیت فرآیند تولید و شرایط نگهداری محصول هستند.
1. شمارش کل میکروارگانیسمها
TVC تعداد میکروبهای زنده و قابل رشد در غذا را نشان میدهد. اگرچه پاتوژنها را مستقیماً مشخص نمیکند، اما شاخص مهمی برای ارزیابی کیفیت و بهداشت تولید است و معمولاً اولین قدم در آزمایش میکروبی محسوب میشود.
2. شمارش کپک و مخمر
این تست به ویژه در مواد غذایی با رطوبت بالا، نانواییها و لبنیات اهمیت دارد. افزایش کپک و مخمر میتواند باعث فساد زودهنگام، تغییر طعم و تولید سموم قارچی شود و ایمنی غذا را تهدید کند.
3. انتروباکتریاسه
وجود این گروه باکتریها معمولاً نشانه ضعف در بهداشت فرآیند تولید یا آلودگی پس از فرآوری است و به عنوان یک شاخص مهم کنترل آلودگی به کار میرود.
۴. شمارش کلیفرمها
کلیفرمها گروهی از باکتریها هستند که بهعنوان شاخص آلودگی مدفوعی و وضعیت بهداشت آب و تجهیزات استفاده میشوند. وجود آنها معمولاً نشاندهنده نقص در بهداشت فرآیند تولید، شستوشو یا ضدعفونی است و یک هشدار اولیه برای ایمنی میکروبی غذا محسوب میشود.
۵. اشریشیا کلی (Escherichia coli – E. coli)
E. coli شاخص دقیقتر و جدیتر آلودگی مدفوعی است و حضور آن میتواند نشاندهنده خطر مستقیم برای سلامت مصرفکننده باشد. شناسایی این باکتری معمولاً به مشکلات اساسی در بهداشت آب، نیروی انسانی یا آلودگی ثانویه اشاره دارد و نقش مهمی در ارزیابی ایمنی میکروبی مواد غذایی دارد.
تستهای شناسایی میکروارگانیسمهای بیماریزا
این تستها برخلاف تستهای شمارشی، مستقیماً میکروبهای بیماریزا را شناسایی میکنند. حتی حضور کم این پاتوژنها میتواند سلامت مصرفکننده را به خطر بیندازد.
6. سالمونلا
یکی از مهمترین عوامل مسمومیت غذایی در جهان است. میتواند در محصولات خام یا فرآوریشده وجود داشته باشد و نبود آن در تستها حیاتی است.
7. لیستریا مونوسایتوژنز
بهویژه در محصولات آماده مصرف خطرناک است، چون حتی در یخچال رشد میکند. کنترل آن برای زنان باردار و سالمندان اهمیت زیادی دارد.
8. استافیلوکوکوس اورئوس
این باکتری سم مقاوم به حرارت تولید میکند که حتی پس از پخت هم خطرناک باقی میماند. شناسایی آن بخش مهم آزمایش میکروبی است.
9. باسیلوس سرئوس
اغلب در غذاهای نشاستهای و آماده دیده میشود و میتواند باعث مسمومیت حاد شود.
10. کلستریدیومها
گونههایی مثل C. perfringens و C. botulinum از خطرناکترین پاتوژنها هستند. نبود آنها در نتایج تستها کاملاً حیاتی است.
تستهای شاخص بهداشتی
این تستها مستقیماً پاتوژنها را شناسایی نمیکنند، بلکه برای ارزیابی شرایط بهداشتی محیط تولید و فرآیندهای کنترلی استفاده میشوند و نقش پیشگیرانه مهمی دارند.
11. ارزیابی بهداشت محیط تولید
با این تستها میتوان سطح آلودگی سطوح، تجهیزات و محیط تولید را بررسی و نقاط بحرانی را شناسایی کرد.
12. کنترل فرآیندهای شستوشو و ضدعفونی
این تستها نشان میدهند که فرآیندهای شستوشو و ضدعفونی بهدرستی انجام شده یا نیاز به اصلاح دارند.
13. بررسی آلودگی ثانویه
آلودگی ثانویه یکی از بزرگترین چالشهای صنایع غذایی است و تستهای شاخص کمک میکنند منابع آن شناسایی و کنترل شوند.
روشهای انجام تستهای میکروبیولوژی مواد غذایی
تستهای میکروبیولوژی معمولاً به دو دسته تقسیم میشوند: روشهای کلاسیک (کشت میکروبی) و روشهای سریع و نوین.
انتخاب روش مناسب به نوع محصول، دقت مورد نیاز و زمان در دسترس بستگی دارد.

روشهای کلاسیک (کشت میکروبی)
روشهای کلاسیک ستون اصلی آزمایشهای میکروبی هستند و با محیطهای کشت انتخابی، رشد و شناسایی میکروبها را ممکن میکنند.
محیطهای کشت انتخابی
این محیطها طوری طراحی شدهاند که فقط میکروب مورد نظر رشد کند و دیگر میکروبها محدود شوند. به آزمایشگاهها اجازه میدهد میکروبهایی مثل سالمونلا، E.coli و لیستریا را با دقت بالا شناسایی کنند.
مزایا و محدودیتها
مزایا:
- دقت علمی بالا
- شناسایی و شمارش دقیق میکروبها
- استاندارد و مورد قبول مراجع بینالمللی
محدودیتها:
- زمانبر (گاهی چند روز تا یک هفته)
- نیاز به تجهیزات و نیروی متخصص
- رشد کند بعضی میکروبها
روشهای سریع و نوین
با پیشرفت فناوری، روشهای سریع و نوین جایگاه ویژهای در آزمایش میکروبی مواد غذایی پیدا کردهاند. این روشها با تمرکز بر سرعت، دقت و کاهش هزینه، امکان تشخیص سریع میکروبها و پاتوژنها را فراهم میکنند.
PCR و qPCR
این روشها برای تشخیص مستقیم DNA میکروارگانیسمها استفاده میشوند و حتی وجود تعداد کم پاتوژنها را سریع و با دقت بالا شناسایی میکنند.
ELISA
روش ELISA برای شناسایی پروتئینها یا سموم میکروبها کاربرد دارد و برای تشخیص سموم استافیلوکوکوس اورئوس و باسیلوس سرئوس بسیار مفید است.
تستهای سریع صنعتی
تستهای سریع صنعتی، اغلب به شکل کیتهای آماده هستند و امکان تشخیص فوری میکروبها در خطوط تولید را فراهم میکنند. سرعت عمل بالایی دارند و برای کنترل کیفیت کارخانهها ایدهآلاند.
مقایسه سرعت، دقت و هزینه
| روش | سرعت | دقت | هزینه | کاربرد |
| کشت کلاسیک | کند (چند روز) | بسیار دقیق | متوسط-بالا | شناسایی استاندارد و دقیق میکروبها |
| PCR/qPCR | سریع (چند ساعت) | بسیار دقیق | متوسط | تشخیص سریع DNA پاتوژنها |
| ELISA | سریع | دقیق | متوسط | شناسایی سموم و پروتئینها |
| تست سریع صنعتی | خیلی سریع (چند دقیقه–چند ساعت) | متوسط-خوب | پایین–متوسط | کنترل خط تولید و تشخیص فوری |
مراحل استاندارد انجام آزمایش میکروبی مواد غذایی
برای اطمینان از ایمنی و کیفیت غذا، آزمایش میکروبی باید طبق مراحل استاندارد انجام شود تا نتایج دقیق و قابل اعتماد باشند.
- نمونهبرداری اصولی
نمونهبرداری باید نماینده کل محصول باشد و آلودگی اضافی ایجاد نشود.
- استفاده از ابزار استریل
- رعایت دستورالعملهای ISO و FDA
- انتخاب تعداد و حجم مناسب نمونه
نمونهبرداری دقیق، پایه تمام مراحل بعدی است.
- انتقال و نگهداری نمونه
انتقال و نگهداری صحیح، جلوگیری از تغییر تعداد میکروبها قبل از آزمایش را تضمین میکند.
- نگهداری در دمای مناسب (۴–۸°C)
- استفاده از ظروف استریل و بستهبندی مناسب
- انجام آزمایش در سریعترین زمان ممکن
- پیشتکثیر
هدف افزایش تعداد میکروبهای موجود در نمونه قبل از کشت انتخابی است، مخصوصاً برای پاتوژنهای کم تعداد.
- استفاده از محیط مناسب رشد اولیه
- رعایت زمان و دما طبق استاندارد
- آمادهسازی نمونه برای کشت نهایی و تستهای شناسایی
- کشت و شناسایی
در این مرحله، میکروبها در محیطهای انتخابی رشد داده شده و شناسایی میشوند.
- محیط کشت اختصاصی برای هر پاتوژن
- بررسی خصوصیات کلنیها و صفات میکروبها
- ترکیب روشهای کلاسیک و سریع (PCR، ELISA) برای دقت بیشتر
- تأیید نتایج
این مرحله برای اطمینان از دقت و صحت آزمایشها است.
- انجام آزمایش تکراری یا کنترل مثبت و منفی
- بررسی تطابق با استانداردهای بینالمللی
- ثبت دقیق نتایج و گزارشدهی
استانداردها و حدود مجاز در تستهای میکروبی مواد غذایی
برای اطمینان از ایمنی و کیفیت غذا، تستهای میکروبیولوژی باید بر اساس استانداردهای بینالمللی و ملی انجام شوند. رعایت این استانداردها تضمین میکند که نتایج قابل اعتماد و معتبر باشند و محصولات غذایی مطابق با قوانین عرضه شوند.
استانداردهای ISO
ISO استانداردهای جهانی برای آزمایش میکروبی ارائه میدهد، شامل نمونهبرداری، کشت، شناسایی و تعیین حدود مجاز میکروبها. رعایت آنها امکان مقایسه و ارزیابی بینالمللی را فراهم میکند.
نمونههای پرکاربرد:
- ISO 6579: تشخیص سالمونلا
- ISO 4833: شمارش کل میکروارگانیسمها
- ISO 21528: بررسی کلیفرمها و E.coli
استاندارد Codex
Codex Alimentarius مجموعهای از استانداردهای جهانی است که توسط FAO و WHO منتشر شده است و بهویژه برای کشورهایی که صادرات دارند حیاتی است.
مزایا:
- تعیین حدود مجاز برای پاتوژنها و میکروبهای شاخص
- ارائه راهنمایی برای نمونهبرداری و آزمایش
- تضمین همخوانی با قوانین بینالمللی
استانداردهای ملی
هر کشور ممکن است استانداردهای ملی مخصوص خود داشته باشد که معمولاً بر اساس ISO و Codex تدوین میشوند. این استانداردها میتوانند شامل:
- حداکثر کلونیها (TVC)
- میزان مجاز کلیفرمها و E.coli
- محدودیت برای پاتوژنهای مشخص
اشتباهات رایج در تستهای میکروبیولوژی مواد غذایی
حتی بهترین آزمایشگاهها گاهی ممکن است اشتباه کنند. شناخت و جلوگیری از این خطاها، کلید دقت و اعتمادپذیری نتایج است.

نمونهبرداری اشتباه
نمونهبرداری حساسترین مرحله است. نمونه غیرنماینده یا ابزار آلوده میتواند نتایج را مخدوش کند.
نکات کلیدی:
- استفاده از ابزار استریل
- انتخاب نمونه نماینده از کل محصول
- رعایت دما و زمان مناسب در انتقال
بدون نمونهبرداری صحیح، حتی بهترین تجهیزات هم ممکن است نتایج غلط یا گمراهکننده بدهند.
تفسیر نادرست نتایج
تفسیر اشتباه دادهها میتواند خطرساز باشد، حتی اگر آزمایشها درست انجام شده باشند.
اشتباهات رایج:
- تشخیص نادرست کلنیها یا پاتوژنها
- نادیده گرفتن شاخصهای هشداردهنده مانند میزان کلیفرمها
- مقایسه نادرست با استانداردهای ISO یا Codex
تفسیر علمی و دقیق، کلید ارزیابی واقعی ایمنی و کیفیت غذا است.
اعتماد کور به تستهای سریع
روشهای سریع مانند PCR، ELISA یا کیتهای صنعتی مفیدند، اما جایگزین کامل روشهای کلاسیک نمیشوند.
خطرات اعتماد بیش از حد:
- شناسایی ناقص برخی میکروبها
- عدم تشخیص نمونههای با بار میکروبی کم
- ایجاد اعتماد کاذب به ایمنی محصول
بهترین راه، ترکیب روشهای کلاسیک و سریع همراه با نمونهبرداری اصولی و تفسیر دقیق است تا دقت و اعتبار نتایج تضمین شود.
سوالات پرتکرار
- تست میکروبی مواد غذایی چقدر زمان میبرد؟
مدت زمان تست میکروبی بستگی به روش مورد استفاده دارد:
- روش کلاسیک (کشت میکروبی): معمولاً ۲–۷ روز
- روشهای سریع مانند PCR یا ELISA: چند ساعت تا یک روز
به عبارت ساده: هر چه سرعت بالاتر، جزئیات کمتر؛ هر چه روش دقیقتر، زمان بیشتر.
- آیا همه محصولات غذایی نیاز به تست دارند؟
تقریباً تمام محصولات غذایی نیاز به تست دارند، مخصوصاً محصولات خام یا آماده مصرف. شدت و نوع تست بسته به محصول و ریسک آن متفاوت است:
- محصولات خام (گوشت، سبزیجات، لبنیات) → تست جامع
- محصولات فرآوری شده و پخته → تست نمونهگیری و کنترل کیفیت
- محصولات کمریسک (نمک، شکر) → تست محدود یا شاخص
- تفاوت تست سریع و کشت چیست؟
| ویژگی | روش کلاسیک (کشت) | روش سریع (PCR، ELISA، کیت صنعتی) |
| سرعت | چند روز | چند ساعت |
| دقت | بسیار دقیق | دقیق تا خوب |
| کاربرد | شناسایی و شمارش کامل میکروبها | تشخیص سریع پاتوژنها و سموم |
| محدودیت | زمانبر، نیاز به متخصص | ممکن است بعضی میکروبها را نشان ندهد |
جمعبندی
تستهای میکروبیولوژی مواد غذایی ستون اصلی ایمنی و کیفیت هر محصول غذایی هستند. بدون آنها، هیچ تولیدکنندهای نمیتواند با اطمینان کامل از سلامت محصولاتش حرف بزند و هیچ مصرفکنندهای هم نمیتواند به غذای خود اعتماد کند.
در این مقاله یاد گرفتیم:
- چگونه تستهای میکروبی میتوانند مسمومیتهای غذایی را پیشگیری کنند.
- اهمیت رعایت استانداردهای ISO، Codex و ملی برای تولید محصول ایمن.
- انواع تستها و کاربرد هر کدام: شمارشی، شناسایی پاتوژنها و شاخصهای بهداشتی.
- روشهای کلاسیک و نوین و مقایسه سرعت، دقت و هزینه آنها.
- مراحل استاندارد آزمایش و اشتباهات رایجی که باید از آنها اجتناب کرد.
اگر شما تولیدکننده، متخصص آزمایشگاه یا حتی یک مصرفکننده حرفهای هستید، این مقاله میتواند یک مرجع کامل و قابل اعتماد برای درک اهمیت میکروبیولوژی مواد غذایی باشد و به شما کمک کند تصمیمهای درست و ایمنی بگیرید.




